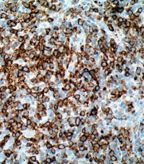

A new study has identified independent risk factors for the development of non-Hodgkin lymphoma (NHL) including high fetal growth, older age of the mother, low birth order, and male sex. A family history of NHL in either parent or sibling was found to be the strongest risk factor.
A new study has identified independent risk factors for the development of non-Hodgkin lymphoma (NHL) including high fetal growth, older age of the mother, low birth order, and male sex. A family history of NHL in either parent or sibling was found to be the strongest risk factor. Male sex was only associated with NHL risk up to age 15, but not for later-onset NHL. Gestation age at birth, twinning, age of the father, and parental education were not associated with NHL risk. The large national cohort study is published in the Journal of the National Cancer Institute.
Cutaneous anaplastic large-cell lymphoma, a type of NHL, on histology
Lead author Casey Crump, department of medicine at Stanford University in California, and colleagues aimed to identify risk factors for NHL as childhood and adolescent NHL rates have steadily increased over the last 50 years. NHL rates almost doubled between 1975 and 2000 in the United States. Better screening methods only partially explain the rise in numbers and perinatal factors have been proposed to contribute to the risk.
The cohort consisted of more than 3.5 million people born in Sweden between 1973 and 2008. The subjects were followed for NHL incidence until 2009. Data such as perinatal and family characteristics, and NHL diagnosis timing were obtained through national birth and cancer registries. The study authors found that both genetics and in utero conditions contributed independently to NHL development. There were 936 NHL cases identified in the cohort. Sweden has detailed and complete national registries facilitating a study of this scale and allowing for a robust analysis of early life development and risk factors.
“We identified multiple risk factors for NHL in early life, which can help shed light on underlying causes,” said Casey Crump. According to Crump, one of the most surprising findings was the link between high fetal growth and NHL. “Most previous data have shown no effect. But those data were derived mainly from case-control studies of birth weight and may not have had adequate specificity or control for confounding to observe an effect with fetal growth,” explained Crump. While the mechanism is not well established, Crump speculated it may involve increased levels of fetal growth factors that can enhance tumor growth.
A second surprising result, according to Crump, is the association of low birth order and NHL. “This was in contrast to various smaller studies and is consistent with the ‘delayed exposure hypothesis,’” said Crump. This hypothesis postulates that delayed infectious exposures, resulting from an absence of older siblings, can result in impaired maturation of the immune system which could predispose a child to develop NHL.
The higher incidence of NHL among males is not explained well, said Crump. He added that he is not aware of a diagnosis bias that could potentially explain the skew in statistics.
NHL has many different origins and can involve genetic factors, the Epstein-Barr virus, immunodeficiency disorders, and environmental factors, among others. Because of the climb in NHL diagnoses in children and young adults, there is an interest in understanding the perinatal risk factors to better identify high-risk infants to provide better early detection and treatment.
A limitation of the study is the missing environmental risk factors such as pollutants, contaminants, and radiation that likely vary by geography. An accompanying editorial by William F. Anderson, MD, MPH, and Benjamin Emmanuel, MPH, the Division of Cancer Epidemiology and Genetics at the National Cancer Institute, highlights this limitation but emphasizes the importance and scale of the study which maximizes the ability to generalize the conclusions to different populations.
“Our findings suggested that there are important unmeasured environmental factors, which indeed vary in different places and will need further investigation in different populations,” said Crump. He added that the underlying mechanism for early-onset NHL are likely to be similar among industrialized countries in North America and Europe.
“We hope that our findings will lead to additional research into environmental and genetic risk factors for NHL in this population and others,” said Crump. “Pooled studies of sibling pairs would be a helpful next step to elucidate gene–environment interactions.”